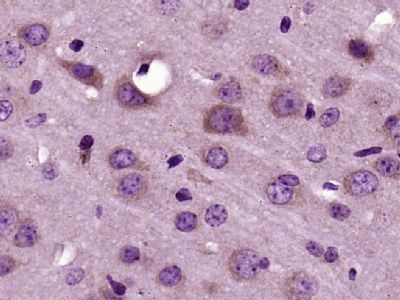
RNF128 antibody

相关产品推荐更多 >
万千商家帮你免费找货
0 人在求购买到急需产品
- 详细信息
- 文献和实验
- 技术资料
- 供应商:
上海康朗生物科技有限公司
- 库存:
大量
- 目录编号:
kl-9251R
- 克隆性:
多克隆
- 抗原来源:
Rabbit
- 保质期:
12个月
- 抗体英文名:
RNF128 antibody
- 抗体名:
环指蛋白128抗体
- 宿主:
Rabbit
- 适应物种:
Human, Mouse, Rat, Chicken, Dog, Pig, Cow, Zebrafish,
- 免疫原:
KLH conjugated synthetic peptide derived from human RNF128:151-260/428
- 亚型:
IgG
- 形态:
冻干粉或液体
- 应用范围:
WB=1:500-2000 ELISA=1:500-1000 IHC-P=1:400-800 IHC-F=1:400-800 IF=1:50-200
- 浓度:
1mg/ml
- 保存条件:
-20 °C
- 规格:
100ul 200ul
| 中文名称 | 环指蛋白128抗体 |
| 别 名 | E3 ubiquitin protein ligase RNF128; E3 ubiquitin-protein ligase RNF128; FLJ23516; Gene related to anergy in lymphocytes protein; GRAIL; ring finger protein 128; RN128_HUMAN; RNF128. |
| 规格价格 | 100ul/1380元 购买 200ul/2200元 购买 大包装/询价 |
| 说 明 书 | 100ul 200ul |
| 研究领域 | 细胞生物 免疫学 |
| 抗体来源 | Rabbit |
| 克隆类型 | Polyclonal |
| 交叉反应 | Human, Mouse, Rat, Chicken, Dog, Pig, Cow, Zebrafish, |
| 产品应用 | WB=1:500-2000 ELISA=1:500-1000 IHC-P=1:400-800 IHC-F=1:400-800 IF=1:50-200 (石蜡切片需做抗原修复) not yet tested in other applications. optimal dilutions/concentrations should be determined by the end user. |
| 分 子 量 | 43kDa |
| 细胞定位 | 细胞浆 |
| 性 状 | Lyophilized or Liquid |
| 浓 度 | 1mg/ml |
| 免 疫 原 | KLH conjugated synthetic peptide derived from human RNF128:151-260/428 |
| 亚 型 | IgG |
| 纯化方法 | affinity purified by Protein A |
| 储 存 液 | 0.01M TBS(pH7.4) with 1% BSA, 0.03% Proclin300 and 50% Glycerol. |
| 保存条件 | Store at -20 °C for one year. Avoid repeated freeze/thaw cycles. The lyophilized antibody is stable at room temperature for at least one month and for greater than a year when kept at -20°C. When reconstituted in sterile pH 7.4 0.01M PBS or diluent of antibody the antibody is stable for at least two weeks at 2-4 °C. |
| PubMed | PubMed |
| 产品介绍 | background: The protein encoded by this gene is a type I transmembrane protein that localizes to the endocytic pathway. This protein contains a RING zinc-finger motif and has been shown to possess E3 ubiquitin ligase activity. Expression of this gene in retrovirally transduced T cell hybridoma significantly inhibits activation-induced IL2 and IL4 cytokine production. Induced expression of this gene was observed in anergic CD4(+) T cells, which suggested a role in the induction of anergic phenotype. Alternatively spliced transcript variants encoding distinct isoforms have been reported. [provided by RefSeq, Jul 2008]. Function: E3 ubiquitin-protein ligase that catalyzes polyubiquitin chains. Functions as an inhibitor of cytokine gene transcription. Inhibits IL2 and IL4 transcription and this activity is likely to be mediated by E3 ligase activity. Plays an important role in the induction of the anergic phenotype. Functions in the patterning of the dorsal ectoderm; sensitizes ectoderm to respond to neural-inducing signals. Subcellular Location: Endomembrane system; Single-pass membrane protein. Cytoplasm, perinuclear region. Note=Localized in an asymmetric perinuclear punctuate manner. Localizes to the internal pool of the transferrin recycling endosomal pathway. Partially colocalized with the endoplasmic reticulum resident HSPA5, with Golgi resident STX5, and with the late endosomal GTPase RAB7A. Post-translational modifications: Auto-ubiquitinated. Controls the development of T-cell clonal anergy by ubiquitination. Similarity: Contains 1 PA (protease associated) domain. Contains 1 RING-type zinc finger. SWISS: Q8TEB7 Gene ID: 79589 Database links: Entrez Gene: 79589 Human Entrez Gene: 66889 Mouse Entrez Gene: 315911 Rat Omim: 300439 Human SwissProt: Q8TEB7 Human SwissProt: Q9D304 Mouse Unigene: 496542 Human Unigene: 27764 Mouse Important Note: This product as supplied is intended for research use only, not for use in human, therapeutic or diagnostic applications. |
| 产品图片 |  Paraformaldehyde-fixed, paraffin embedded (Mouse stomach); Antigen retrieval by boiling in sodium citrate buffer (pH6.0) for 15min; Block endogenous peroxidase by 3% hydrogen peroxide for 20 minutes; Blocking buffer (normal goat serum) at 37°C for 30min; Antibody incubation with (RNF128) Polyclonal Antibody, Unconjugated (bs-9251R) at 1:400 overnight at 4°C, followed by operating according to SP Kit(Rabbit) (sp-0023) instructionsand DAB staining.  Paraformaldehyde-fixed, paraffin embedded (Rat brain); Antigen retrieval by boiling in sodium citrate buffer (pH6.0) for 15min; Block endogenous peroxidase by 3% hydrogen peroxide for 20 minutes; Blocking buffer (normal goat serum) at 37°C for 30min; Antibody incubation with (RNF128) Polyclonal Antibody, Unconjugated (bs-9251R) at 1:400 overnight at 4°C, followed by operating according to SP Kit(Rabbit) (sp-0023) instructionsand DAB staining. Paraformaldehyde-fixed, paraffin embedded (Mouse brain); Antigen retrieval by boiling in sodium citrate buffer (pH6.0) for 15min; Block endogenous peroxidase by 3% hydrogen peroxide for 20 minutes; Blocking buffer (normal goat serum) at 37°C for 30min; Antibody incubation with (RNF128) Polyclonal Antibody, Unconjugated (bs-9251R) at 1:400 overnight at 4°C, followed by operating according to SP Kit(Rabbit) (sp-0023) instructionsand DAB staining.  Tissue/cell: HepG2 cell; 4% Paraformaldehyde-fixed; Triton X-100 at room temperature for 20 min; Blocking buffer (normal goat serum, C-0005) at 37°C for 20 min; Antibody incubation with (RNF128) Polyclonal Antibody, Unconjugated (bs-9251R) 1:200, 90 minutes at 37°C; followed by a conjugated Goat Anti-Rabbit IgG antibody (bs-0295G-FITC) at 37°C for 90 minutes, DAPI (5ug/ml, blue, C-0033) was used to stain the cell nuclei. |
风险提示:丁香通仅作为第三方平台,为商家信息发布提供平台空间。用户咨询产品时请注意保护个人信息及财产安全,合理判断,谨慎选购商品,商家和用户对交易行为负责。对于医疗器械类产品,请先查证核实企业经营资质和医疗器械产品注册证情况。
 文献和实验
文献和实验Generation of Antibody Molecules Through Antibody Engineering
been overcome to a large extent using genetic-engineering techniques to produce chimeric mouse/human and completely human antibodies. Such an approach is particularly suitable because of the domain structure of the antibody molecule ( 2 ), where functional
The importance of antibody molecules was first recognized in the 1890s, when it was shown that immunity to tetanus and diphtheria was caused by antibodies against the bacterial exotoxins (1 ). Around the same time, it was shown that antisera
General comments: Antibodies, like most proteins, do not like to be freeze-thawed. Avoid repetitive freezing of your solution. The best way to store your antibody is to keep a high protein concentration (>1 mg/ml), add some protease
 技术资料
技术资料暂无技术资料 索取技术资料








